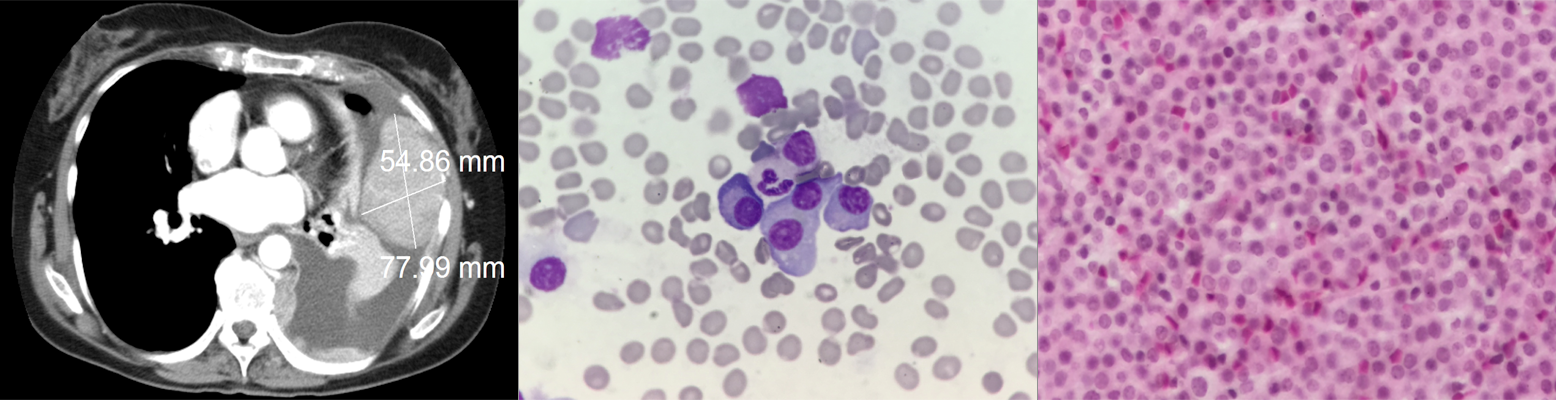

A 70-year-old woman with no history of smoking or asbestos exposure presented with dyspnea on exertion, nonproductive cough, left-sided pleuritic chest pain, and fatigue. Chest radiography revealed a large left pleural effusion and a mass in the left lower lobe. What is the diagnosis?
A 70-year-old woman with no history of smoking or asbestos exposure presented with dyspnea on exertion, nonproductive cough, left-sided pleuritic chest pain, and fatigue. Chest radiography revealed a large left pleural effusion and a mass in the left lower lobe. Chest CT confirmed a pleural-based mass of 7.8 × 5.5 cm invading the anterior chest wall. A left-sided thoracentesis revealed a bloody, lymphocyte-predominant exudative pleural effusion, with a white blood cell count of 8,144/μL (26% lymphocytes, 2% neutrophils, 3% monocytes, and 69% other cell-line types). A cytologic examination of the pleural fluid and a biopsy of the pleural mass were performed, followed by aspiration and biopsy of the bone marrow.
What is the diagnosis?
This study presents a male breast cancer case with a germline BRCA2 mutation and discusses the epidemiologic, pathologic, and clinical characteristics along with treatment and follow-up recommendations in view of our recent understanding of the disease.
Oncology Peer Review On-The-Go: COVID-19, Cancer, and the Potential of mRNA Vaccines
March 30th 2021Mehmet Sitki Copur, MD, discussed his article in the Journal ONCOLOGY® focusing on COVID-19, messenger RNA vaccines, and the excitement surrounding its integration into the future of cancer treatment.
ABSTRACT: Breast metastasis from extramammary malignancy is rare, with a reported incidence rate of 0.4% to 1.3% in the published literature. The primary malignancies that most commonly metastasize to the breast are leukemia, lymphoma, and malignant melanoma. Here, we report a very rare case of metastatic EGFR-mutated non–small cell lung cancer (NSCLC) in the breast detected by screening mammography. The patient had initially been diagnosed with a clinical stage IIIA NSCLC and had been treated with neoadjuvant chemoradiation followed by curative-intent surgery. Several interesting aspects of the case, along with a discussion of evolving adjuvant and frontline metastatic management options in EGFR-mutated NSCLC, will be presented.
Locally Advanced Gastrointestinal Stromal Tumor in a 33-Year-Old Woman Seeking to Conceive
ABSTRACT Gastrointestinal stromal tumors (GISTs) are rare neoplasms of the gastrointestinal tract. They commonly present with nonspecific symptoms and thus are often discovered incidentally. They are best identified by CT scan and most stain positive for CD117 (C-Kit), CD34, and/or DOG-1. Several risk stratification classification systems have been developed based on tumor size, mitotic rate, location, and perforation. Traditional chemotherapy and radiation therapy have been very ineffective, making surgery the mainstay of treatment. The discovery of mutations associated with these tumors has revolutionized the treatment approach. Imatinib mesylate, a selective tyrosine kinase receptor inhibitor, used as adjuvant or neoadjuvant therapy, has greatly improved the morbidity and mortality associated with GISTs. As the survival of patients has increased with the long-term use of targeted therapies, quality-of-life issues now have become much more relevant and have come to the forefront of care. We present a young woman who was successfully treated for GIST but now faces associated long-term adverse effects of imatinib, including the challenge of preserving fertility and the potential for childbearing.